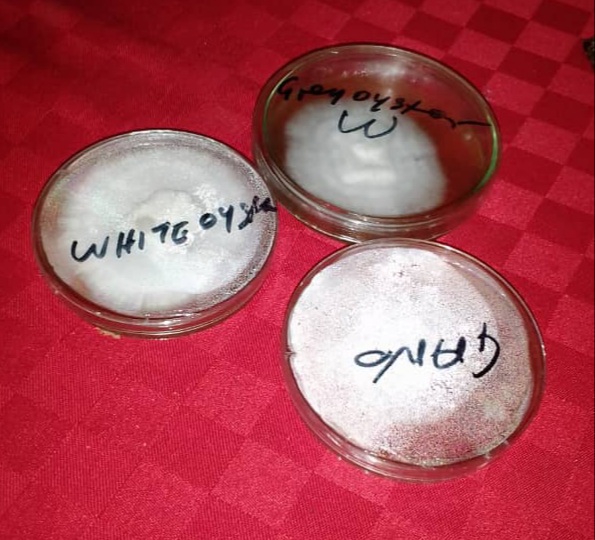

Our Products
Home / Our Products
Innovation with Impact
From farm-fresh mushrooms to processed and packaged options, we deliver quality products that are convenient and nutritious.
Explore our range of value-added mushroom products:

Mushroom Value Addition

Mushroom Tea Bags

Dried Organic Vegetables

Commercial Urban Farming

Solar Dryer Fabrication
Spawn Production

Mushroom Snacks

Mushroom Powder

